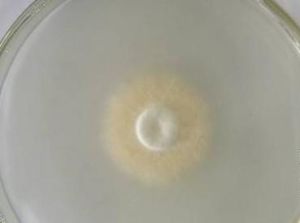
球孢蟲科 球孢蟲科

名稱
球孢蟲科
分類地位
球孢蟲科(Sphaerosporidae)是原生動物門、粘體動物亞門、粘孢子蟲綱、雙殼目的一科。
形態特徵
在孢子縫面觀常為球形,殼面為紡錘形或與其相近似的形狀。孢子具極
球孢蟲科主要屬
我國有1屬,球孢蟲屬(Sphaerospora Thelohan,1892)。
球孢蟲科是原生動物門的一種,形態主要是在孢子縫面觀常為球形,殼面為紡錘形或與其相近似的形狀。孢子具極囊2個,位於一端,排列在縫面的垂直面上。球孢蟲科,是一種生物學學科的一種專有名詞。
球孢蟲科
球孢蟲科(Sphaerosporidae)是原生動物門、粘體動物亞門、粘孢子蟲綱、雙殼目的一科。
在孢子縫面觀常為球形,殼面為紡錘形或與其相近似的形狀。孢子具極
球孢蟲科我國有1屬,球孢蟲屬(Sphaerospora Thelohan,1892)。
貝氏等孢球蟲(Isospora belli)廣泛寄生於人及哺乳類、鳥類和爬行類動物的腸道內。 [形態與生活史] 貝氏等孢球蟲的卵囊(圖8-30a,b,c...
形態 形態與生活史 致病與診斷] 流行與防治鰱球孢蟲(學名:Sphaerospora i)為球孢科球孢蟲屬的動物。 在中國,分布於湖北等,營寄生生活,寄生在鰱的腎。
9306拉丁目名: 球孢科拉丁科名: 球孢蟲屬拉丁屬名:
9305拉丁目名: 球孢科拉丁科名: 球孢蟲屬拉丁屬名:
9308拉丁目名: 球孢科拉丁科名: 球孢蟲屬拉丁屬名:
9307拉丁目名: 球孢科拉丁科名: 球孢蟲屬拉丁屬名:
9309拉丁目名: 球孢科拉丁科名: 球孢蟲屬拉丁屬名:
: 單極亞目中文科名: 球孢科拉丁科名: Sphaerosporidae中文屬名: 球孢蟲屬拉丁屬名: Sphaerospora...年代: 1998中文名:鯇球孢蟲 ...
